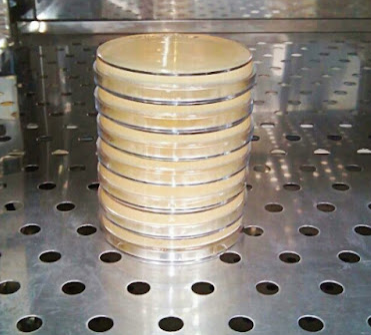
inverted petri dish - Inverted Petri dishImage source:Sandeep Dhiman

The Petri dish, also called thePetri plate or the cell-culture dish was invented in 1887 by the German bacteriologist Julius Richard Petri. He was the assistant of the most renowned bacteriologist Robert Koch. Before the invention of the Petri dish, microorganisms were cultured in glass jars, liquor bottles, and test tubes. Petri dish provides a broader surface area for growing the organism than tubes and bottles.
**A Petri dish is essentiallaboratory equipmentfor the growth of microorganisms in the artificial solid culture media.**A Petri dish consists of two parts: the smaller one is a container, and the larger is a lid. The larger dish fits over, the smaller dish and forms a cap. The commonly used Petri dish in a laboratory has a diameter of 90 mm.
Types
Different Petri dishes are available based on materials, size, and compartments.
Materials

Petri dishes are made from glass or plastic. Usually, glass Petri dishes are made from borosilicate glass, and plastic Petri dish from polystyrene or polycarbonate. The glass Petri dishes are reusable, while the plastic Petri dishes are discarded after use. Plastic Petri dishes are lighter than glass Petri dishes, which makes them easy to handle.
Size

The commonly used Petri dish in the laboratory has a 90 mm diameter. Petri dishes are available in different sizes like 35 mm, 50 mm, 60 mm, 90, 100 mm, 150 mm, etc., which vary according to the purpose of the laboratory work.
Compartments

Some Petri dishes have different compartments in which partition is made so that more than one culture media plate can be prepared in a single plate. These plates are of various sizes, having 2, 3, or 4 compartments.
Uses
- Petri dish prepares the culture media plates for growing the microorganisms. It provides the proper place for the growth of microorganisms and cells and prevents them from contamination. These culture media supports the growth of microorganisms and help to isolate and identify them from various clinical, food, and environmental samples. Various plating techniques are used for determining the viable microbial count and isolation of bacteria using the Petri dish.
- Petri plate is transparent because it is made from clear glass or plastic. So, microorganisms can be observed and studied from outside the plate too.
- It is used to store the preserved microorganism for a certain time. Cultured media plates can be easily wrapped with parafilm tape or aluminum foil and stored in the refrigerator.
- The equipment is used to grow skin grafts and organoids.
- Petri plate is used to study the early phases of plant germination.
- It is used for the study of insects and their behavior.
- The instrument is used in the chemistry lab to evaporate the solvent and dry the precipitates.
How to use a Petri dish?
In the laboratory, Petri dishes are used for various purposes. Before using it, ensure the plates are clean and sterile.
Sterilizing plates
Plastic Petri dishes come in a sealed pack already sterilized during manufacture. You can open and use it directly in the aseptic condition.
If you are using reusable glass Petri dishes, you must sterilize them after each use. The standard method of sterilizing glass Petri dishes is dry heat sterilization using a hot air oven at 160 ℃ for 120 min. After sterilizing glass Petri dishes, turn off the hot air oven and let the plates cool down.
Culture media plate preparation
Then you can pour the sterile molten culture media. The suitable culture media provides the essential nutrients and ingredients to facilitate microbial growth. After pouring the appropriate media, allow it to settle. Normally 25 ml media is poured into the 90 mm Petri dish. Then molten agar starts to solidify at about 42°C.
Storage
Store the prepared culture media plates at 4℃ in the refrigerator. Generally, prepared culture media can be stored for up to three weeks.
Inoculation and incubation
Before using stored culture media, bring them to room temperature. If there is moisture in the plates, dry them for some minutes in the hot air oven orincubator by slightly opening the lid of the plates at a temperature of around 30℃-35 ℃. Be sure not to dry it for a long time too.
Label the media plates at the bottom, inoculate the specimens, and incubate the plates in an incubator in an inverted position. Most of the pathogenic bacteria of humans are mesophilic. So they are incubated overnight at 37℃. The fungi plates are incubated at both 28℃ and 37℃. Then the colony morphology and cultural characteristics of the microorganisms are studied from which the microorganisms can be identified.
Discard
To discard used culture media plates, sterilize them in the autoclave at 121℃ for 15 min. A reusable glass Petri dish can be washed, dried, sterilized, and used again, whereas plastic Petri plates are discarded after sterilization.
Why is the Petri dish incubated in the inverted position?
- The Petri dish with the culture media is incubated in an inverted position to avoid the droplets from falling into the media due to the condensation of the vapor. These droplets can cause contamination.
- It prevents the media from drying. If a plate is kept in a normal position without inverting it, water starts to evaporate from the culture media, hindering the growth and isolation of the microorganisms.
- Placing the Petri dish in the inverted position also prevents contamination from airborne particles.
- Never pour the media at a higher temperature because it can cause excessive moisture in the plates because of more vapor. So pour the media on the plates when it cools down to a temperature of about 45℃.
Why is the Petri dish always labeled at the bottom?
If you label the Petri dish or the culture media plates on the lid, swapping the lid changes the source/origin of the isolate. This may lead to false reporting laboratory. So to avoid these conditions, the Petri dish is always labeled on the bottom of the plate, not on the lid.
Automated Petri dish filler

Preparing and dispensing the media into the Petri dish in the laboratory by a manual method is time-consuming, and there is a higher chance of contamination. This problem can be solved using automated Petri dish fillers manufactured and marketed by companies like Systec, INTEGRA Biosciences, Neutec Group BT900000, etc. These Petri-dish fillers can fill about a hundred to thousand plates in an hour.
References
- Mahajan, M. (2021). Etymologia: Petri Dish. Emerging Infectious Diseases, 27(1), 261. https://doi.org/10.3201/eid2701.et2701.
- Edwards, C. (2022). The Petri dish: telling the story of pharma’s most humble ally. Pharmaceutical Technology. Retrieved 12 October 2022, from https://www.pharmaceutical-technology.com/analysis/the-petri-dish-telling-the-story-of-pharmas-most-humble-ally/.
- 4 Compartment Petri Dish at Thomas Scientific. Thomassci.com. (2022). Retrieved 12 October 2022, from https://www.thomassci.com/scientific-supplies/4-Compartment-Petri-Dish.
- Sigmaaldrich.com. (2022). Retrieved 12 October 2022, from https://www.sigmaaldrich.com/NP/en.